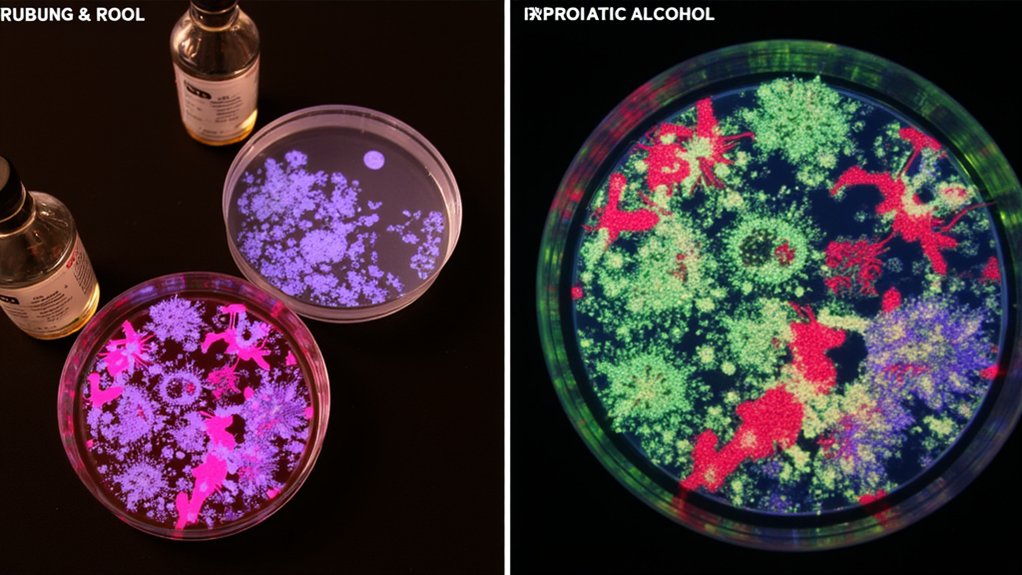

You might be surprised to learn that 70% rubbing alcohol actually works better as a disinfectant than 90% strength. While you’ll find various concentrations at the store, scientists have discovered that the perfect balance occurs when water molecules help alcohol penetrate bacterial cell membranes more effectively. Understanding how to properly use this common household disinfectant can mean the difference between simply cleaning a surface and truly sanitizing it.
What Makes Rubbing Alcohol an Effective Disinfectant

Because rubbing alcohol contains a high concentration of either isopropyl or ethyl alcohol, it effectively kills bacteria, viruses, and other harmful microorganisms through a process called denaturation.
The disinfectant properties of rubbing alcohol work best when the concentration is between 60% and 90%. “At these levels, alcohol molecules break down protein structures in bacteria and viruses,” explains Dr. Sarah Chen, microbiologist at Stanford University. You’ll find rubbing alcohol’s effectiveness peaks at 70%, as this concentration allows the solution to penetrate cell membranes more effectively.
Key factors that make rubbing alcohol an effective disinfectant:
- Rapid evaporation prevents bacterial growth
- No residue left behind
- Breaks down microorganism cell membranes
- Works quickly (typically within 10-30 seconds)
- Cost-effective compared to specialized cleaners
The Science Behind Different Alcohol Concentrations

While many people assume higher alcohol concentrations are always better for disinfecting, the science behind alcohol’s effectiveness reveals a more nuanced reality.
The ideal concentration for rubbing alcohol falls between 70-91%. Here’s why: When you’re using alcohol concentrations above 91%, the alcohol evaporates too quickly for effective alcohol absorption into bacterial cells. Meanwhile, concentrations below 70% don’t pack enough punch to destroy harmful microorganisms.
Key concentration effects:
- 70% – Ideal balance of potency and absorption time
- 80% – Strong germ-killing power, moderate evaporation
- 91% – Maximum strength, but requires quick application
- >91% – Evaporates before full disinfection occurs
- <70% - Too diluted for reliable sanitization
- Most harmful bacteria (E. coli, Salmonella)
- Many fungi and mold species
- Some viruses (including influenza)
- Bacterial spores
- Certain antibiotic-resistant bacteria
- Some viruses (like norovirus)
- Clean the surface first with soap and water
- Let the area dry completely
- Apply rubbing alcohol using a clean cloth or spray bottle
- Use enough to thoroughly wet the surface
- Allow 30 seconds of contact time for proper disinfection
- Let air dry naturally – don’t wipe
- Always work in a well-ventilated area
- Keep away from open flames and heat sources
- Wear protective gloves to prevent skin irritation
- Store in a cool, dark place out of children’s reach
- Using on sensitive surfaces without testing first
- Mixing with other cleaning chemicals
- Applying near electrical outlets or equipment
- Forgetting to cap the bottle tightly after use
- Using around open wounds or broken skin
- Bleach solution (1:10 ratio with water) for non-porous surfaces
- Hydrogen peroxide (3%) for kitchen counters and bathroom fixtures
- Vinegar solution (equal parts water and white vinegar) for general cleaning
- Quaternary ammonium compounds for electronics and delicate surfaces
- Steam cleaning for fabrics and upholstery
For best results, you’ll want to choose a 70% solution, which provides the perfect balance of killing power and contact time.
Types of Germs Rubbing Alcohol Can and Cannot Kill
Although rubbing alcohol effectively kills many common pathogens, you’ll need to understand its limitations before relying on it as your primary disinfectant.
What Rubbing Alcohol Kills:
What Rubbing Alcohol Doesn’t Kill:
Dr. Sarah Chen, infectious disease specialist, explains: “While alcohol disrupts bacterial cell membranes effectively, some pathogens have developed bacterial resistance mechanisms.” You’ll need additional disinfection methods to prevent germ transmission in high-risk areas. For thorough protection, combine alcohol-based cleaning with other EPA-approved disinfectants, especially in areas where spore-forming bacteria or resistant pathogens may be present.
Proper Application Methods for Maximum Effectiveness
To get the maximum germ-killing power from rubbing alcohol, you’ll need to follow specific application methods backed by scientific research.
Key application techniques:
Surface preparation is vital for effectiveness. “The presence of dirt or debris can shield microorganisms from the alcohol’s disinfecting properties,” explains Dr. Sarah Chen, infectious disease specialist. You’ll want to verify at least 70% concentration and maintain wet contact for the full recommended time. For vertical surfaces, apply from top to bottom to prevent streaking and verify complete coverage.
Safety Precautions and Common Mistakes to Avoid
Proper application of rubbing alcohol must be balanced with key safety considerations to protect both you and your surfaces. “Many people don’t realize that rubbing alcohol is highly flammable and its fumes can be dangerous in enclosed spaces,” warns Dr. Sarah Chen, toxicologist.
Key Safety Guidelines:
Common Pitfalls to Avoid:
Alternative Disinfectants When Alcohol Isn’t Suitable
Since rubbing alcohol isn’t appropriate for all disinfecting needs, you’ll want to keep several effective alternatives in your cleaning arsenal. “We recommend having at least 2-3 different EPA-registered disinfectants at home for various surfaces and situations,” explains Dr. Sarah Chen, infectious disease specialist.
Here are reliable alternatives for different scenarios:
“Choose your disinfectant based on the surface material and level of contamination,” advises Dr. Chen. Remember to check product labels for specific contact times and compatibility with different materials.
Frequently Asked Questions
Can Rubbing Alcohol Damage or Discolor My Clothes While Disinfecting Surfaces?
You’ll want to be cautious as rubbing alcohol can damage fabric dyes and weaken fibers. For stain removal and fabric safety, avoid contact with clothes while disinfecting surfaces.
How Long Does Rubbing Alcohol Remain Effective After Opening the Bottle?
While 70% rubbing alcohol lasts 3+ years unopened, you’ll get about 2-3 years of shelf life after opening if you’re storing it properly. Keep it tightly sealed in cool, dark storage conditions.
Is Mixing Different Types of Rubbing Alcohol Safe?
You shouldn’t mix different rubbing alcohol concentrations, as it’s unsafe and unpredictable. Always follow safety precautions and use products as they come, without combining different types or strengths.
Can I Use Rubbing Alcohol to Clean Fresh Wounds?
Don’t use rubbing alcohol on fresh wounds as it can damage healing tissue. Instead, try wound care alternatives like sterile saline solution or mild soap and water for safer cleaning.
Does Storing Rubbing Alcohol in Hot Places Affect Its Disinfecting Properties?
Like fragile flowers wilting in summer heat, your rubbing alcohol’s strength diminishes in hot storage. You’ll want to keep it in a cool, dark place to maintain its temperature sensitivity and follow storage guidelines.
